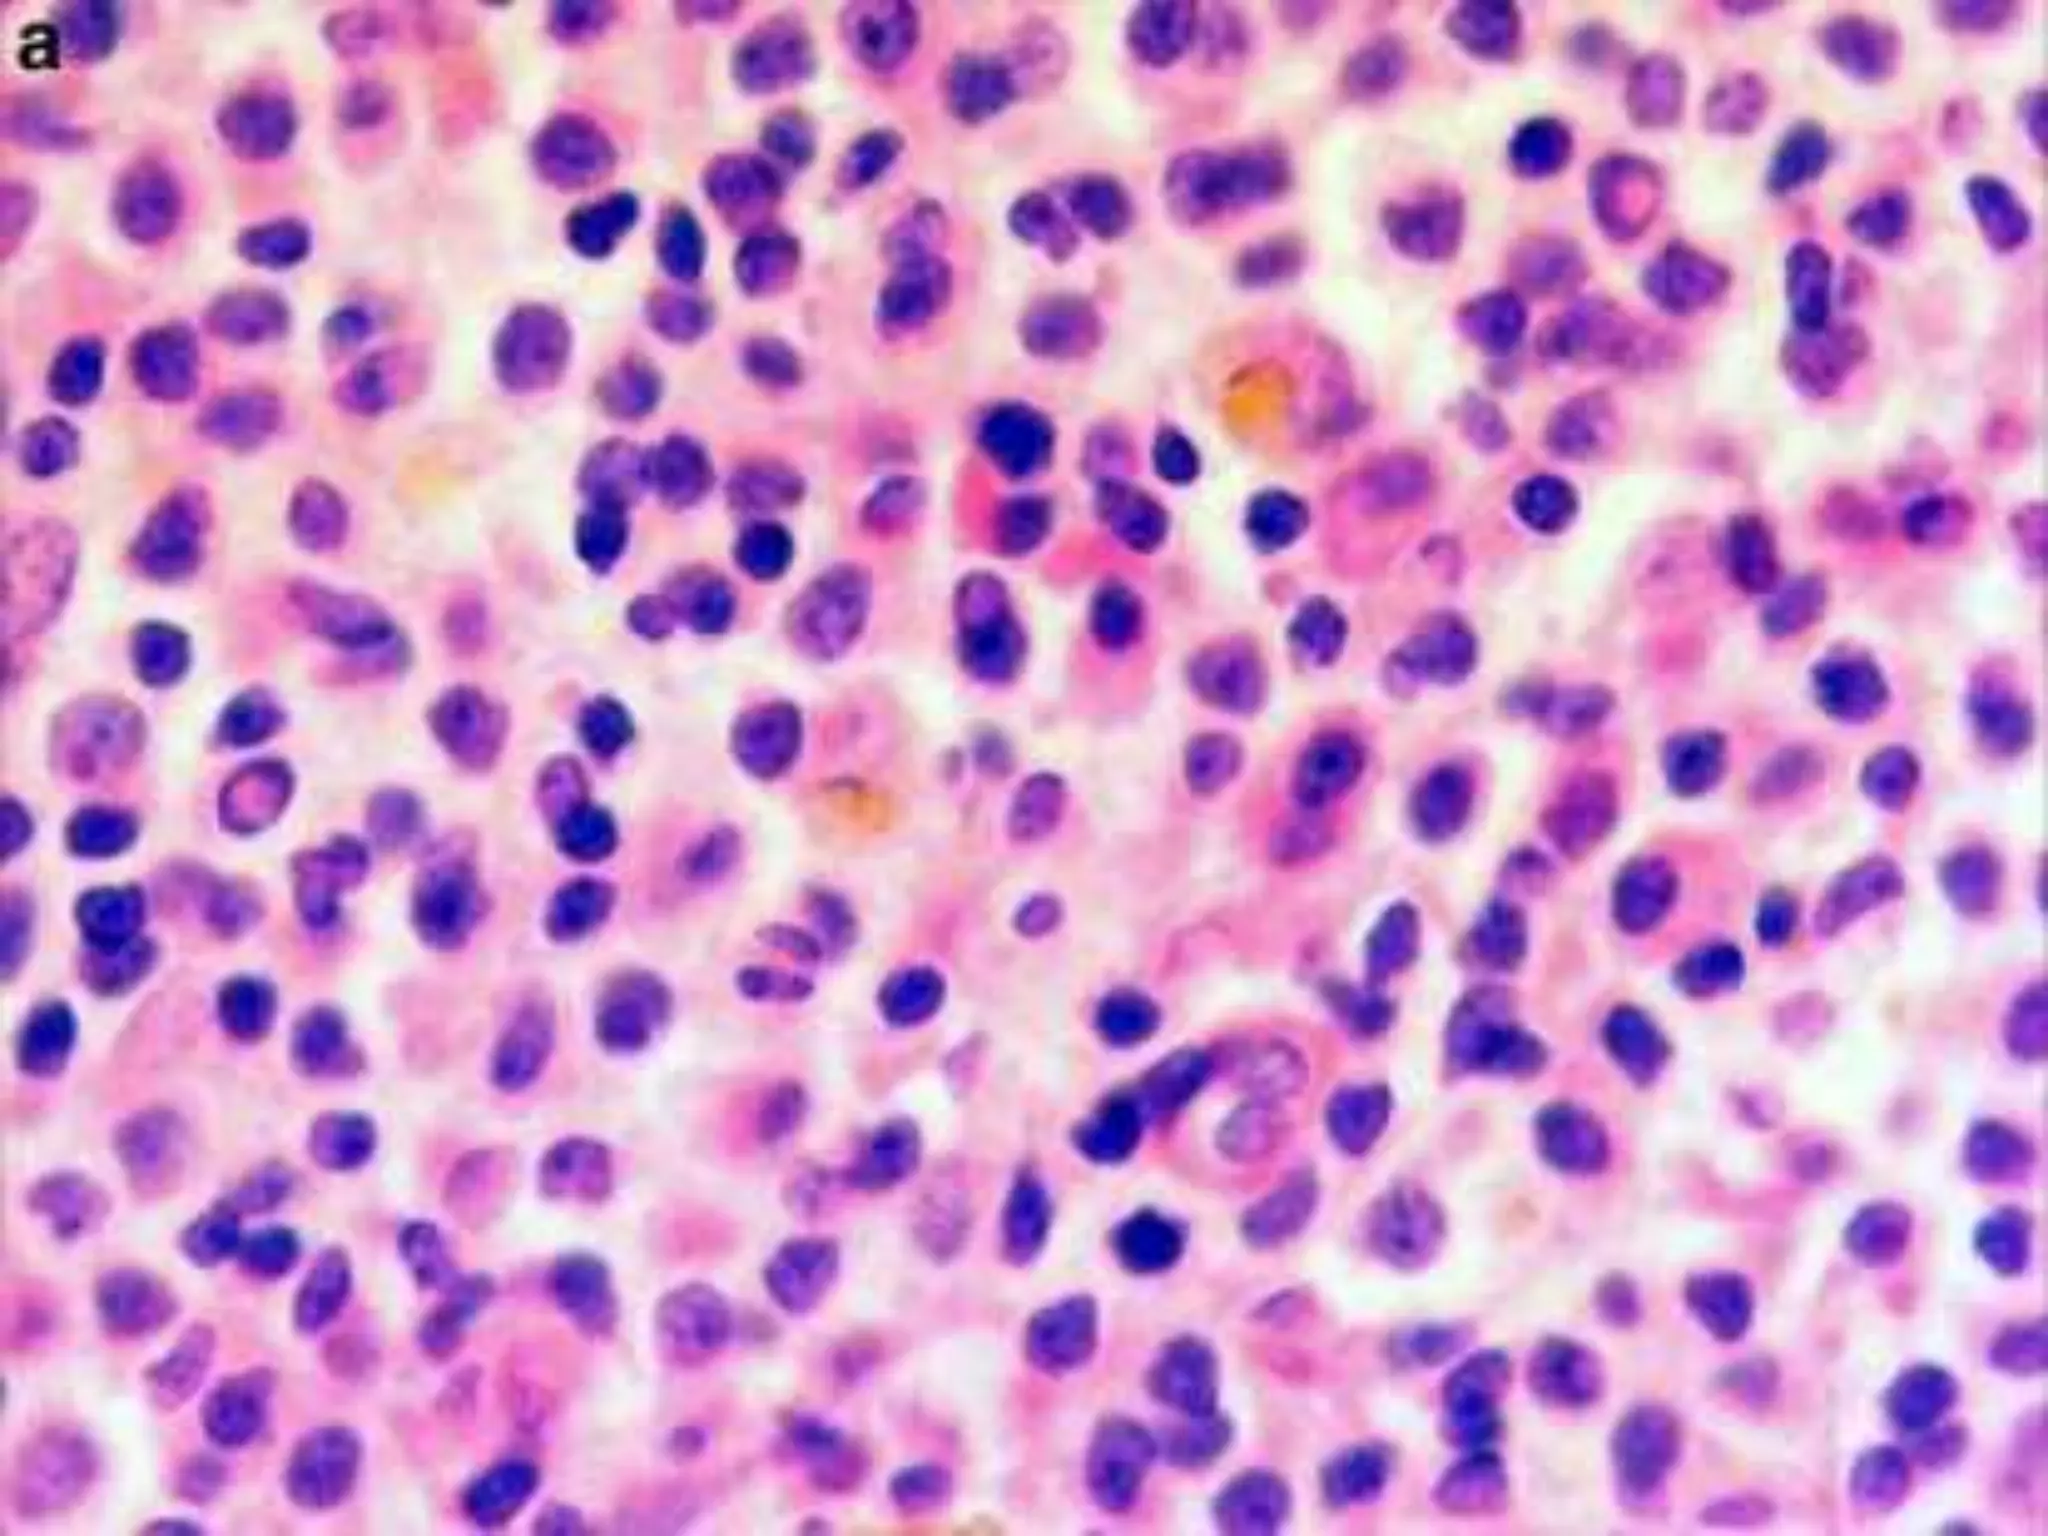

The document discusses plasma cell disorders, focusing on multiple myeloma and Waldenström macroglobulinemia, which are characterized by the proliferation of B-cell clones producing abnormal immunoglobulins. It highlights the clinical features, laboratory findings, diagnostic methods, and prognostic factors associated with these conditions. Multiple myeloma is notably linked to skeletal destruction and widespread organ infiltration, whereas Waldenström is recognized for its hyperviscosity syndrome and affects older adults.